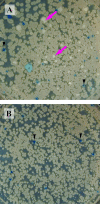

Tracing the domestication of a biofilm-forming bacterium
- PMID: 21278284
- PMCID: PMC3133032
- DOI: 10.1128/JB.01542-10
Tracing the domestication of a biofilm-forming bacterium
Abstract
Over the course of more than a century of laboratory experimentation, Bacillus subtilis has become "domesticated," losing its ability to carry out many behaviors characteristic of its wild ancestors. One such characteristic is the ability to form architecturally complex communities, referred to as biofilms. Previous work has shown that the laboratory strain 168 forms markedly attenuated biofilms compared with the wild strain NCIB3610 (3610), even after repair of a mutation in sfp (a gene involved in surfactin production) previously known to impair biofilm formation. Here, we show that in addition to the sfp mutation, mutations in epsC, swrA, and degQ are necessary and sufficient to explain the inability of the laboratory strain to produce robust biofilms. Finally, we show that the architecture of the biofilm is markedly influenced by a large plasmid present in 3610 but not 168 and that the effect of the plasmid can be attributed to a gene we designate rapP. When rapP is introduced into 168 together with wild-type alleles of sfp, epsC, swrA, and degQ, the resulting repaired laboratory strain forms biofilms that are as robust as and essentially indistinguishable in architecture from those of the wild strain, 3610. Thus, domestication of B. subtilis involved the accumulation of four mutations and the loss of a plasmid-borne gene.
Figures

References
-
- Branda S. S., Chu F., Kearns D. B., Losick R., Kolter R. 2006. A major protein component of the Bacillus subtilis biofilm matrix. Mol. Microbiol. 59:1229–1238 - PubMed
Publication types
MeSH terms
Substances
Grants and funding
LinkOut - more resources
Full Text Sources
Other Literature Sources
Molecular Biology Databases

